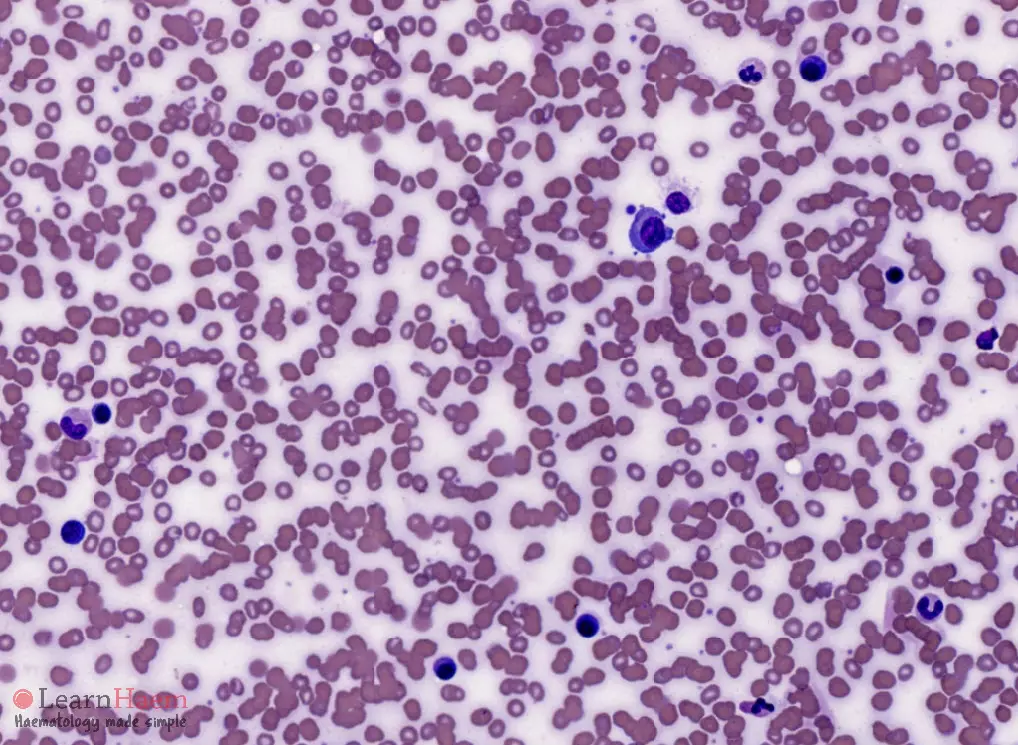

Multiple myeloma is characterised by the proliferation of clonal plasma cells, usually resulting in the production of a paraprotein and end-organ damage. The diagnostic criteria for multiple myeloma were set out by the International Myeloma Working Group in 2014 (Rajkumar et al., 2014).
Diagnostic Criteria
- Bone marrow plasma cells >10% or biopsy-proven bony or extramedullary plasmacytoma; and
- Any one of the following evidence of end-organ damage or myeloma-defining events:
- Hypercalcemia: serum calcium >0.25 mmol/L higher than the upper limit of normal or >2.75 mmol/L.
- Renal insufficiency: creatinine clearance <40 mL/min or serum creatinine >177mol/L.
- Anemia: hemoglobin value of >2g/dL below the lowest limit of normal, or a hemoglobin value <10g/dL.
- Bone lesions: one or more osteolytic lesion on skeletal radiography, CT, or PET/CT. If bone marrow has <10% clonal plasma cells, more than one bone lesion is required to distinguish from solitary plasmacytoma with minimal marrow involvement.
- Bone marrow plasma cells >60%.
- Serum involved / uninvolved free light chain ratio of 100 or greater, provided the absolute level of the involved light chain is at least 100mg/L.
- More than one focal lesion on MRI that is at least 5mm or greater in size.
Peripheral Blood Features
- Rouleux formation
- Increased backgroudn staining
- May have circulating plasma cells (rare)
0 x
0 x
0 x
Bone Marrow Features





- Plasma cell >10%
- Plasma cell infiltrate may be patchy. Distribution may be in:
- Diffuse sheets.
- Interstitial.
- Small clusters.
- Focal nodules.
- Plasma cells may range from normal in appearance to immature with dispersed nuclear chromatin and prominent nucleoli (plasmablasts).
- Other abnormalities in plasma cells can be seen, but note that these are not pathognomonic of myeloma and can also be seen in reactive plasma cells:
- Multinuclearity.
- Flame cells (vermillion-staining glycogen-rich IgA).
- Pseudo-Gaucher cells (overstuffed fibrils).
- Russell bodies (cherry-red refractive, round bodies of crystallised immunoglobulins).
- Mott cells which contain Russell bodies.
0 x
0 x
0 x
0 x
Thank you